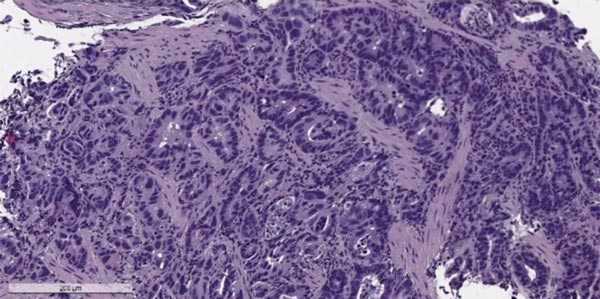
Карцинома желудка

Симптомы и признаки рака желудка
Добавил пользователь Morpheus Обновлено: 09.01.2026
Рак желудка достаточно распространенное онкологическое заболевание. Но выявить его на ранней стадии практически невозможна – клиническая картина сглажена, патологию легко перепутать с обычным недомоганием. Поэтому важно периодически проходить осмотр и при малейшем подозрении на рак провести качественное лечение.
Типичные симптомы рака желудка
Хотя симптомы рака желудка в начальной фазе не дают выраженной картины, можно выявить патологию до осложнения болезни метастазированием. Для этого необходимо периодически проходить профилактические осмотры, особенно если имеется генетическая предрасположенность к заболеванию.
Нередко пациенты предпочитают диагностику и терапию онкологии желудка, прочих видов опухолей, например, лечение рака груди за границей. Подсказать, что злокачественное образование развилось именно в тканях желудка, помогут типичные признаки.
У пациента в комплексе проявляется следующая картина:
Если систематически проявляются перечисленные симптомы, следует в кратчайшие сроки обратиться к гастроэнтерологу и пройти развернутое обследование. Лучше проводить лечение рака желудка за границей, так как именно в зарубежных клиниках, по статистике, добиваются максимального положительного результата.
В зависимости от симптоматики выделяют несколько характерных форм рака желудка:
- Диспепсическая. Характеризуется потерей аппетита, ощущением тяжести в эпигастрии, тошнотой и позывами к рвоте, нарушениями стула, икотой, изжогой, отрыжкой с горьким привкусом.
- Болевая. Основной признак наличие болезненных ощущений. Нередко патологию путают с язвой желудка.
- Лихорадочная. В этом случае врачи могут предположить, что требуется лечение рака костей за границей, так как повышение температуры при онкологии часто сопровождает поражение скелетных тканей. В случае рака желудка отмечается субфебрильная температура, по утрам значения нередко достигают 38–40 градусов. Прочие признаки практически отсутствуют.
- Анемическая. В равной степени проявляются гипохромия либо гиперхромия. Прочие признаки мало выраженные.
- Геморрагическая. Характерны желудочные кровотечения, рвота. При этом массы, исторгаемые органом, напоминают кофейную гущу.
Так как симптоматика чаще носит невыясненный характер, только опытный врач сможет на основании признаков поставить точный диагноз. В Израиле обследование дает 100% результат, так как используются современные методы, высокоточная аппаратура.
Нетипичные симптомы рака желудка
Клиническая картина рака желудка нередко затрудняется неспецифическими признаками:
Подобная картина нередко становится причиной путаницы, врачи, не находя характерной симптоматики, отметают диагноз «рак желудка».
Первые симптомы рака желудка
Так на какие систематические признаки следует обращать внимание, чтобы выявить онкологию уже при раннем развитии?
К ним относят:
Однако следует учитывать, что даже первая невыраженная симптоматика различается в зависимости от места расположения опухоли.
Симптомы при опухоли среднего отдела
Так, при поражении среднего отдела наблюдают:
- Потерю массы тела, слабость, бледность кожи.
- Пропадает аппетит, человек становится безразличным.
Даже если не требуется лечение рака за границей, следует обратиться к врачу, чтобы выяснить причины недомогания.
Симптомы в антральном отделе
Когда злокачественное образование поразило нижний отдел, характерными становятся следующие симптомы:
- Тошнота и рвотные позывы. Чаще всего именно на эти признаки рака желудка жалуются пациенты при посещении врача. Симптом провоцируется застоем желудочного секрета и пищи в результате сужения области перехода органа в 12-перстную кишку.
- Тяжесть в подложечной области.
- Наличие неприятного аромата из ротовой полости.
- Горькая отрыжка.
Если рвотные массы окрашены в темный цвет, значит, патология сопровождается кровотечением, пациент подлежит немедленной госпитализации.
Как отличить симптомы рака желудка от язвы?
К сожалению, неясная клиническая картина приводит к путанице – нередко вместо рака желудка диагностируют язвенное образование. В результате терапия не оказывает положительного эффекта, онкология прогрессирует и ее выявляют, когда опухоль вышла за пределы органа.
Особенно часто это происходит, если именно язвенная болезнь стала причиной рака.
Тем не менее, можно определить момент преобразования язвы в злокачественную опухоль, если внимательно отнестись к появлению таких симптомов:
В этом случае стоит пройти внеочередную диагностику, скорее всего, начался злокачественный процесс.
Диагностика рака желудка на ранней стадии проблематична. Но если имеются подозрения на онкологию, лучше пройти обследование и терапию за рубежом. Для примера можно привести цифры – в Японии онкология данного типа выявляется на ранней стадии у 40% больных. В России этот показатель не превышает 10%. Конечно, во многом это зависит от пациентов, которые не придают внимание незначительному дискомфорту в эпигастральной зоне. В результате злокачественное образование разрастается, выходит за пределы органа, метастазирует в грудную клетку, кишечник, пищевод и гортань.
Для своевременного выявления первых симптомов заболевания нужно проходить диагностические осмотры в специализированных медицинских центрах. Чтобы попасть за границу для диагностики и лечения рака желудка, необходимо обратиться к оператору координационного центра, который занимается оформлением поездок медицинских туристов. Сотрудник выберет клинику, где терапия рака желудка проходит с высоким результатом, по желанию клиента подберет вариант с меньшими затратами.
Терять время не стоит, так как порой онкологический процесс развивается стремительно. При обращении в заграничные больницы не придется долго ожидать очереди на процедуры. Диагностика занимает всего несколько суток, непосредственно после нее врачи приступают к лечению.
Боли при раке
С каждым годом число онкологических больных растет, рак все чаще диагностируется у молодых людей. Получили самую высокую распространенность среди онкологических заболеваний рак легких, рак молочной железы и рак кишечника. В России у мужчин лидируют рак легких, рак предстательной железы и рак кожи. У женщин наиболее часто встречаются рак молочной железы, рак кожи и рак шейки матки.
Лечением онкологических заболеваний в Москве занимаются в клинике онкологии Юсуповской больницы, где представлена мощная диагностическая база, инновационное оборудование, в штате отделения работают опытные высокопрофессиональные специалисты по лечению и диагностике рака.
При раке желудка
Боли в животе при раке желудка появляются при развитии опухоли, на ранней стадии рак желудка ничем себя не проявляет. Определить место локализации первичной опухоли можно по времени. Если боль появляется сразу после еды – опухоль расположена рядом с пищеводом. Появление боли через час говорит о раке дна желудка, через полтора-два часа о раке привратника. Если боль распространяется в область плеча, поясницы, отдает в область сердца – это говорит о начале метастазирования опухоли.
Боли в спине при раке желудка – это также показатель метастазирования опухоли. Течение заболевания может проходить без боли, а может сопровождаться болью разной интенсивности. Боли могут быть слабовыраженными и ноющими, колющими и внезапными, ярко выраженными, режущими. Боль может сопровождаться чувством распирания, быть давящей, постоянной. При раке желудка боли могут быть не связаны с приемом пищи, присутствуют постоянно, могут быть сильными или слабыми, вызывают снижение аппетита.
При раке легких
Боли в груди при раке легких могут появиться из-за нескольких причин: опухоль дала метастазы в костные ткани, опухоль имеет большой размер, сдавливает и повреждает соседние ткани и органы, поражается легочная стенка, боль возникает внутри злокачественной опухоли легкого. Боль при раке легкого может быть острой, резкой при кровоизлиянии в опухоль, хронической на поздних стадиях развития заболевания.
Метастатический рак легкого характеризуется болевыми ощущениями в бедрах и спине, онемением конечностей, головокружением, головной болью, отеком регионарных лимфатических узлов в области плеча, отеком кожи и другими симптомами. Нарушение дыхательной функции, стенокардические боли, тахикардия, постоянные мучительные боли связаны с распространением раковой опухоли.
При раке молочной железы
Рак молочной железы редко сопровождается болью. На ранней стадии развития рак молочной железы не проявляется симптомами, рост опухоли проходит незаметно. В отличие от кисты, которая очень болезненна при пальпации, раковая опухоль при пальпации не болезненна.
Болью сопровождается одна из форм агрессивного рака – диффузно-инфильтративного рака молочной железы. Он протекает как хронический нелактационный мастит, молочная железа опухает, кожный покров краснеет, появляется боль. Болезненность сосков появляется при раке Педжета.

array(6) < ["ID"]=>string(5) "27236" ["WIDTH"]=> int(1024) ["HEIGHT"]=> int(682) ["SRC"]=> string(62) "/upload/sprint.editor/eae/abb8b65fe88df22935694eb141cf0901.jpg" ["ORIGIN_SRC"]=> string(62) "/upload/sprint.editor/eae/abb8b65fe88df22935694eb141cf0901.jpg" ["DESCRIPTION"]=> string(0) "" >
При раке мочевого пузыря
Боли при раке мочевого пузыря у мужчин появляется вместе с нарушением мочеиспускания. Злокачественное новообразование приводит к увеличению размера мочевого пузыря. Увеличившийся мочевой пузырь сдавливается между лобковой костью и отделом прямой кишки – это вызывает постоянные болезненные позывы к мочеиспусканию.
Боль при раке мочевого пузыря отдает в область паха, пояснично-крестцовый отдел, надлобковую область. При развитии затруднений с дефекацией появляется боль в области прямой кишки – это говорит о распространении процесса на кишечник. При метастазировании опухоли мочевого пузыря начинают болеть кости таза и позвоночника, появляются проблемы с потенцией.
Боль в спине
Почти у 1% пациентов, жалующихся на боль в спине, врачи диагностируют онкологическое заболевание. Боль в поясничном отделе у женщин может быть симптомом рака яичников, рака простаты и мочевого пузыря у мужчин.
Метастазирование злокачественной опухоли в костные ткани вызывает боли в области спины, конечностей. Боль в спине может быть симптомом рака поджелудочной железы, рака легких.
После химиотерапии
Проведение лечения с помощью химиотерапии при раке может привести к развитию боли, иногда очень выраженной. Это связано с воздействием препаратов химиотерапии, содержащих ядовитые вещества (алкалоид барвинка), на нервные окончания, вовлеченные в опухолевый процесс.
При раке матки
Первыми симптомами развития рака матки становятся: обильные белые выделения, зуд, дискомфорт, кровянистые выделения, которые наблюдаются после физических нагрузок.
При развитии опухоли появляется постоянная тянущая боль в нижней части живота, нарушается мочеиспускание, менструальный цикл. Со временем возникает резкая и сильная боль во время движения, она переходит в хроническую форму.
При раке простаты
При раке простаты во время мочеиспускания появляется чувство жжения, нарушается эректильная функция, мучают боли в лобковой области, в области промежности, боль отдает в прямую кишку.
При раке яичников 4 стадии
4 стадия рака яичников – это неизлечимое заболевание, метастазы опухоли распространяются в другие органы и ткани. В большинстве случаев метастазы рака яичников обнаруживаются в печени и легких.
Больная ощущает боль в области паха, нарушается работа ЖКТ, живот вздувается, мучает одышка, тошнота и рвота.
При раке кишечника
Интенсивность и частота боли при раке кишечника зависит от локализации новообразования, от стадии развития рака. На ранней стадии развития опухоли не происходит сильных повреждений тканей и болевой симптом отсутствует.
В некоторых случаях может наблюдаться болезненность при дефекации. На второй стадии развития опухоль распространяется, может частично перекрывать просвет кишечника – боль принимает ноющий постоянный характер. Нередко в это время онкологическое заболевание путают с гастритом, панкреатитом или колитом. Третья стадия сопровождается распространением опухоли и постоянной тупой болью. Во время дефекации она может становиться схваткообразной, резкой. В последней стадии заболевания постоянно присутствует сильная острая боль, которая не исчезает после приема обезболивающих препаратов.
Головная боль
Как болит голова при раке головного мозга? Какая головная боль при опухоли мозга? – эти вопросы волнуют не только пациентов онкологии, а также близких людей, которым приходится ухаживать за родными.
Головная боль – это наиболее частый симптом рака головного мозга. Головная боль может проявляться в виде диффузной, распространяясь по всей голове, а может концентрироваться в одном месте. Чаще всего боль появляется ночью или утром. Появление боли утром говорит о скапливании полости черепа жидкости.
В результате поражения сосудов мозга нарушается отток крови, развивается отек, сопровождающийся головной болью. Боль может усиливаться во время отдыха, она бывает пульсирующей, распирающей, давящей. У больного онемевают части тела, он чувствует головокружение, случаются эпилептические припадки. На поздней стадии развития опухоли приступы боли становятся мучительными, почти не поддаются купированию.
Боли в костях
Боли в костях при онкологии чаще всего появляются при метастазировании опухолей других органов в костную ткань. Распространение заболевания на кости может сопровождаться обменными нарушениями, переломами костей, плохим срастанием костной ткани.
Боль в области щитовидной железы
Боль в горле при онкологии щитовидной железы возникает при глотании пищи и воды – она возникает из-за чрезмерной работы желез, вырабатывающих слизь. Боль может распространяться по шее до ушей, сопровождаться кашлем и хрипотой.
Фолликулярная карцинома щитовидной железы в большинстве случаев не поражает лимфоузлы, но может распространиться в кости и легкие, вызывая соответствующие симптомы. При своевременной диагностике заболевание излечимо.
Почему при онкологии сильные боли
Боли при онкологии 4 стадии связаны с большим поражением тканей опухолью, во время которого происходит поражение нервов, болевых рецепторов. И если на ранних стадиях степень поражения тканей небольшая, то с ростом опухоли усиливается болевой симптом. Выделяют несколько вариантов боли при онкологии:
- боль ноцицептивная. Отражение боли нечеткое, так как органы брюшной полости имеют висцеральную иннервацию. Пациенты, имеющие поражение органов брюшной полости, не могут точно объяснить, где находится источник боли.
- боль нейропатическая. Развивается из-за поражения нервных окончаний и сплетений раковой опухолью, а также в результате лечения с помощью химиотерапии, из-за повреждения периферической нервной системы, головного и спинного мозга.
- боль психогенная. Стрессовое состояние больного может усиливать восприятие боли.
Онкологическое отделение Юсуповской больницы проводит лечение всех видов злокачественных заболеваний. В стационаре больницы пациент проходит диагностику и лечение заболевания. В состав Юсуповской больницы входит стационар и отделение реабилитации. После лечения больной сможет постоянно находиться на связи с лечащим врачом. Записаться на консультацию можно по телефону или через форму обратной связи на сайте.
Карцинома желудка
Карцинома желудка — это рак и второй по частоте из всех злокачественных опухолей, ежегодно он поражает почти 36 тысяч россиян. За последнее десятилетие заболеваемость существенно снизилась, но доля женщин возросла. Сегодня на четырёх больных мужчин приходится три женщины. В большинстве случаев болезнь развивается у переживших 50-летие.
Причины возникновения и факторы риска
Причины злокачественного новообразования слизистой желудка окончательно не выяснены.
Несомненна роль генетической предрасположенности в сочетании с определённой моделью питания, поскольку опухолевый процесс часто поражает целые народы: японцев, чилийцев, китайцев и корейцев. Американцы и австралийцы, наоборот, болеют нечасто. Россияне тяготеют к группе часто болеющих.
Замечено повышение частоты желудочной карциномы у долго страдающих атрофическим или гиперпластическим гастритом и некоторыми видами полипов, в инициации которых замечена хеликобактерная инфекция — заражение бактерией H.Pylori.
К несомненным факторам риска рака отнесена резекция желудка по поводу любого заболевания. Связь карциномы с язвой желудка совсем не очевидна. Пока больше данных за то, что язва не перерождается в рак, а на ранних этапах един механизм образования патологии слизистой оболочки и некоторые формы рака внешне неотличимы от язвы, поэтому разобраться «что есть что» можно только с помощью биопсии.
Часто новообразование развивается при длительном дефиците витамина В12, как правило, проявляющемся специфической пернициозной анемией и гастритом.
Не доказана пагубная роль вредных привычек — курения и употребления алкоголя, но они способствуют развитию фоновых процессов, к коим причислены все выше описанные заболевания желудочной слизистой.

Симптомы желудочной карциномы
Ранние стадии рака вызывают такие же симптомы, что и любая доброкачественная или воспалительная патология желудочно-кишечного тракта, не вынуждая испытывающего дискомфорт человека обратиться к врачу.
Зачастую вообще нет ни единого признака недуга, поэтому так важно при фоновых процессах регулярно выполнять эндоскопическое обследование ЖКТ.
Желудок растягивается, маскируя уменьшение своей вместимости растущей опухолью, а симптомы не отличаются от банального обострения хронического гастрита, насторожить может только прогрессирующая потеря массы тела при увеличении объёма живота — свидетельство канцероматозного обсеменения брюшной полости с образованием асцита.
Боли типичны для язвы, при раке желудка боли возникают, когда в опухолевый конгломерат запаиваются нервные стволы брюшной полости или вовлекаются соседние органы. Больше половины больных замечают признаки распространённого злокачественного процесса:
- снижение веса,
- увеличение размера живота,
- рвоту после еды,
- появление лимфатических узлов над ключицей или прощупывая уплотнение в подложечной области.
Классификация и разновидности
По клеточному строению подавляющая доля новообразований желудка представлена аденокарциномой, что характерно для всего желудочно-кишечного тракта. Возможны морфологические варианты в виде папиллярной или тубулярной, муцинозной или перстневидно-клеточной аденокарциномы.

Выбор оптимального метода лечения базируется не столько на клеточной разновидности, сколь на степени её агрессивности, то есть дифференцировке, где минимальная обозначается как «высокодифференцированная». Высокая злокачественность присуща низкодифференцированной форме.
Инвазивная карцинома желудка не отдельная болезнь, это естественный процесс развития опухоли, когда она уже не изолированная колония раковых клеток на отдельном участке слизистой оболочки, а внедряется в окружающие ткани, разрушая всё мешающее для её продвижения вглубь и вширь, и обрела способность к метастазированию.
Стадии развития карциномы желудка
Стандартно рак градуируют по стадиям TNM — от первой до четвёртой. Каждой стадии присущ определённый размер первичного очага, который обозначают литерой «Т», и степень вовлечения лимфатических узлов брюшной полости — литера «N». С I по III стадии включительно метастазы в другие органы исключены, то есть «М» всегда только 0.

Схематично и упрощённо стадии трактуются следующим образом:
- Начальные этапы развития, когда раковые клетки не проникли дальше слизистой оболочки, обозначают как ранний рак желудка, то есть карцинома первой стадии или меньше — in situ.
- Метастазы в лимфатические узлы даже при крошечной опухоли, как минимум, вторая стадия.
- Выход карциномы через желудочную стенку в брюшную полость — третья стадия.
- Метастазы рака в другие органы — четвертая.
Профилактика
Профилактика возможна только при ясности причин, приводящих к карциноме. Сегодня онкологам известен список заболеваний, при которых повышена вероятность развития новообразования в слизистой оболочке, но сама первопричина злокачественного перерождения неизвестна.
Профилактика ограничена лечением фоновых болезней желудка и регулярным наблюдением за течением доброкачественных процессов. Ведущий способ скрининга — гастроскопия, позволяющая оценить состояние слизистой оболочки и взять её на анализ.

Для пациентов, перенесших первичное лечение желудочной карциномы, профилактика — это регулярное обследование для раннего обнаружения рецидива опухоли и метастазов.
Диагностика
- Наиболее информативна эндоскопия — эзофагогастроскопия, позволяющая сразу взять для исследования не менее 6 кусочков повреждённой ткани.
- Дополнение гастроскопии УЗИ-исследованием — эндосонография достаточно чётко определит глубину проникновения ракового процесса в желудочную стенку.
- Протяженность поражения стенок органа выясняется при полипозиционном рентгеноконтрастном исследовании.
- КТ брюшной полости выявит метастазы в лимфатической системе и уточнит вовлечение в злокачественный процесс окружающих тканей и органов.
- Обязательное исследование перед операцией — лапароскопия, при которой выявляют канцероматоз брюшины.
Методы лечения и прогнозы
Хирургическое вмешательство при желудочной карциноме — единственный метод радикального лечения. Сегодня предпочтение отдано операциям, позволяющим максимально сохранить органы при безоговорочном удалении всех очагов рака.
Лапароскопические вмешательства по результатам равноценны классическому подходу и позволяют сократить период восстановления.
При раннем раке проводится небольшая эндоскопическая операция, 99% пациентов живут долго и без онкологических проблем.
При первой-второй стадии выполняется резекция. Подавляющее большинство больных с маленькой опухолью проживёт 5 — 10 лет без рецидива заболевания, при второй стадии 5 лет переживает почти две трети оперированных.
При распространении рака за пределы желудка и возможности удаления всего ракового конгломерата проводятся комбинированные операции, включающие резекцию части органа или полное удаление — гастрэктомию. К сожалению, вероятность развития рецидива в этой стадии болезни достаточно высока, поэтому через месяц-полтора после операции начинается профилактическая химиотерапия, длящаяся не менее полугода.
При отсутствии отдалённых метастазов, но технически невозможном удалении опухолевого конгломерата, на первом этапе около 9 недель делают химиотерапию, что в части случаев позволяет выполнить отсроченную операцию, дополняемую в дальнейшем профилактической ХТ. При отсутствии позитивных изменений на фоне лекарственной терапии возможна локальная лучевая терапия, как правило, вместе с изменением схемы химиотерапии.
При метастазах в другие органы операция не показана, хирургическая помощь оказывается только при опасных для жизни осложнениях: кровотечении, фатальном сужении выхода из желудка или перфорации с развитием перитонита. Основной метод лечения — химиотерапия.
При карциноме желудка, как ни при каких других процессах, несомненна высока потребность в паллиативной помощи, в том числе и хирургического плана. Симптоматическая терапия повышает скорость восстановления после операции и химиотерапии, значимо улучшает самочувствие и помогает пациенту с метастазами жить дольше и активнее. В «Евроонко» каждый больной получает не просто оптимальную помощь, но лечение класса «всё самое лучшее из известного».
Злокачественные опухоли желудка: Причины, симптомы и лечение
Рак желудка — это злокачественная опухоль, которая развивается из клеток слизистой оболочки желудка. В России он занимает пятое место по распространенности среди всех видов рака и третье место в структуре смертности. Опухоль может возникнуть в любой части желудка и распространиться в другие органы, чаще всего в пищевод, печень и легкие. Заболевание наиболее распространено среди людей старше 40 лет, мужчины болеют в 1,3 раза чаще женщин. Основной метод лечения – хирургический.
Причины рака желудка
Точные причины рака желудка неизвестны. В слизистой оболочке органа возникают мутации ДНК, и получаются «неправильные» клетки, которые могут приобрести способность к неконтролируемому росту. Почему это происходит — не совсем понятно. Зато хорошо изучены факторы риска — условия, которые повышают риск рака желудка.
Наследственность и рак желудка
Некоторые люди носят в себе «бомбу замедленного действия», спрятанную в генах. Иногда даже не одну. Это подтверждается некоторыми фактами:
- Если у близкого родственника (родители, братья, сестры, дети) человека диагностирован рак желудка, его риски повышены примерно на 20%.
- Мужчины болеют чаще, чем женщины. Сложно сказать, с чем конкретно это связано, но можно предположить, что замешана разница между мужскими и женскими генами.
- Японцы, которые мигрировали в США, болеют раком желудка реже соотечественников, но чаще, чем «коренные» американцы. Это говорит о том, что дело не только в характере питания, но и в наследственности. Главный подозреваемый — ген под названием RNF43. — самый распространенный тип рака желудка — чаще встречается у людей с группой крови A (II), которую они, конечно же, получили вместе с генами.
- Риски повышены при некоторых наследственных заболеваниях: злокачественной анемии (в 3-6 раз), гипогаммаглобулинемии, неполипозном раке толстой кишки.
- Заболеваемость раком желудка повышается после 70 лет: считается, что это происходит из-за того, что с возрастом в клетках тела накапливаются нежелательные мутации.
Рак желудка и характер питания
Роль питания в возникновении злокачественных опухолей желудка изучена хорошо. Риски повышает большое количество соли, крахмала, нитратов, некоторых углеводов. Чаще болеют люди, которые едят много соленых, копченых, маринованных продуктов, мало овощей и фруктов.

Рак желудка и вредные привычки
Курение повышает риск рака желудка примерно вдвое. Ученые в Великобритании считают, что примерно каждый пятый случай связан именно с курением. Когда человек вдыхает табачный дым, часть его попадает в желудок, и содержащиеся в нем вредные вещества повреждают клетки слизистой оболочки. Риски тем выше, чем больше стаж курильщика и ежедневное количество сигарет.
Научные исследования показывают, что употребление алкоголя также повышает риск развития рака желудка. Например, в 2018 году ученые проведи мета-анализ исследований, выполненных с 1995 по 2015 год, и обнаружили, что у людей, регулярно употребляющих спиртное, риск развития злокачественных опухолей в желудке в 1,39 раза выше, чем у непьющих.
Европейское проспективное исследование рака (EPIC Study) показало, что алкоголь стал причиной 57 600 случаев рака верхних отделов пищеварительного тракта, толстой кишки и печени у мужчин и 21 500 случаев у женщин, включенных в это исследование. Среди этих пациентов 57% мужчин регулярно употребляли более двух алкогольных напитков в день, а среди женщин 80% употребляли более одного алкогольного напитка в день. «Один напиток» (standart drink) — это такое количество спиртного в любом виде, которое содержит 14 граммов чистого этилового спирта. Это примерно 350 мл пива (5%), 150 мл вина (12%) или 40–50 мл крепких напитков (40%).
Хеликобактер пилори (H. Pylori) и рак желудка
H. Pylori — бактерия, которая способна вызывать язвенную болезнь и хронический атрофический гастрит. В настоящее время она считается важным фактором развития рака желудка. При хеликобактерной инфекции вероятность возникновения злокачественной опухоли в желудке повышается в 4 раза. В половине удаленных опухолей обнаруживают этого возбудителя.
Другие факторы риска
- Язвенная болезнь. Данные исследований по этому поводу противоречивы. Если язва находится в теле желудка, риск рака повышается почти в 2 раза. При язве нижнего отдела риски, видимо, не повышаются. слизистой оболочки.
- Семейный аденоматозный полипоз – заболевание, вызванное мутацией в гене APC и приводящее к возникновению множества полипов в желудке, кишечнике. При этом незначительно повышается риск рака.
- Перенесенные на желудке операции повышают риск рака в 2,5 раза. Это происходит из-за того, что желудок производит меньше соляной кислоты, и в нем активнее размножаются бактерии, продуцирующие нитриты, происходит обратный заброс желчи из тонкой кишки. Обычно злокачественные опухоли возникают спустя 10-15 лет после хирургического вмешательства.
- Социальное и материальное положение: риск увеличивается при низком уровне доходов, проживании в перенаселенной квартире, без удобств, в неблагоприятном районе.
- Другие онкологические заболевания: рак пищевода, простаты, мочевого пузыря, молочных желез, яичников, яичек.
- Болезнь Менетрие (гипертрофическая гастропатия) характеризуется разрастанием слизистой оболочки желудка, появлением в ней складок и снижением продукции соляной кислоты. Патология встречается редко, поэтому неизвестно, как часто она приводит к раку желудка.
- В группе повышенного риска работники угольной, металлургической и резиновой промышленности.
- Иммунодефицит повышает вероятность развития рака, лимфомы желудка.
Классификация рака желудка: каким он бывает?
Злокачественные опухоли желудка, согласно Международной гистологической классификации ВОЗ, делят на 11 типов, в зависимости от того, из каких клеток они происходят. Преобладает рак из железистых клеток, которые выстилают слизистую оболочку и вырабатывают слизь — аденокарцинома. Он составляет 90-95% всех случаев. Также встречаются опухоли из иммунных (лимфома), гормонпродуцирующих (карциноид) клеток, из нервной ткани.
Одна из старейших классификаций делит злокачественные опухоли желудка на 3 типа:
- Кишечный. Как следует из названия, в окружении опухоли имеется кишечная метаплазия, то есть слизистая оболочка желудка становится похожа на слизистую кишечника. Этот тип рака чаще встречается у пожилых людей, отличается более благоприятным прогнозом. Это типично «японский» тип рака.
- Диффузный. Опухолевые клетки расползаются по стенке желудка, они окружены нормальной слизистой оболочкой.
- Смешанный.
Стадии рака желудка
Рак желудка делят на ранний (начальный) и распространенный. При раннем опухоль не прорастает глубже слизистой оболочки и подслизистой основы. Такие опухоли проще удалить (в том числе эндоскопическим путем), при них лучше прогноз. Также используют классификацию TNM, которая учитывает размеры и прорастание в разные ткани первичной опухоли (T), метастазы в регионарных (близлежащих) лимфатических узлах (N), отдаленные метастазы (M).
Классификация в зависимости от состояния первичной опухоли (T):
- Tx – первичную опухоль невозможно оценить;
- T0 – первичная опухоль не обнаруживается;
- T1 – тяжелая дисплазия клеток слизистой оболочки, опухоль находится в поверхностном слое слизистой оболочки ("рак на месте");
- T2 – опухоль проросла в мышечный слой стенки органа;
- T3 – рак достиг серозной (наружной) оболочки желудка, но не пророс в нее;
- T4 – опухоль проросла в серозную оболочку (T4a), в соседние структуры (T4b).
Классификация в зависимости от наличия поражения в регионарных лимфатических узлах:
- Nx – невозможно оценить метастазы в лимфатических узлах;
- N0 – метастазы в регионарных лимфоузлах не обнаружены;
- N1 – поражены 1-2 лимфоузла;
- N2 – опухолевые клетки распространились в 3-6 лимфоузлов;
- N3 – метастазы в 7-15 (N3a) или в 16 и более (N3b) лимфоузлах.
Классификация в зависимости от наличия отдаленных метастазов:
- M0 – отдаленные метастазы не обнаружены;
- M1 – обнаружены отдаленные метастазы.
Аденокарциному делят на 4 стадии:
- I стадия (T1M0N0 – стадия Ia; T1N1M0, T2N0M0 – стадия Ib). Опухоль находится в пределах слизистой оболочки и подслизистой основы, не прорастает вглубь стенки желудка. Иногда раковые клетки обнаруживают в близлежащих лимфатических узлах.
- II стадия (T1N2M0, T2N1M0, T3N0M0 – стадия IIa; T1N3aM0, T2N2M0, T3N1M0, T4aN0M0 – стадия IIb). Опухоль прорастает в мышечный слой стенки желудка и распространяется в лимфатические узлы.
- III стадия (T2N3aN0, T3N2M0, T4aN1M0, T4aN2M0 – стадия IIIa; T1N3bM0, T2N3bM0, T3N3aM0, T4aN3aM0, T4bN1M0 – стадия IIIb; T3N3bM0, T4aN3bM0, T4bN3aM0 – стадия IIIc). Рак пророс через всю стенку желудка и, возможно, распространился на соседние органы, успел сильнее поразить близлежащие лимфатические узлы.
- IV стадия (любые T и N, M1). Есть отдаленные метастазы.
Метастазы рака желудка
Раковые клетки могут отрываться от материнской опухоли и мигрировать в другие части тела различными путями:
- С током лимфы они могут попасть в лимфатические узлы брюшной полости, а из них — в лимфоузлы надключичной области — метастаз Вирхова. Метастаз в лимфоузлы, окружающие прямую кишку, называют метастазом Шницлера.
- С током крови раковые клетки чаще всего распространяются в печень, реже — в легкие.
- Также раковые клетки могут рассеиваться по брюшной полости. Если они оседают на яичниках, образуется метастаз Крукенберга, в пупке — метастаз сестры Марии Джозеф.Редко при раке желудка обнаруживают метастазы в головном мозге, костях.
Симптомы: как проявляется рак желудка?
Первые проявления рака желудка называются «малыми признаками»:
- Необъяснимая слабость и повышенная утомляемость.
- Плохой аппетит в течение длительного времени.
- Снижение работоспособности.
- Потеря веса без видимых причин.
- «Желудочный дискомфорт»: неприятные ощущения, боли в верхней части живота после приемов пищи.
- Изменение пищевых предпочтений, отвращение к пище, которая раньше нравилась.
- Чувство переполненности, распирания в животе.
Зачастую на ранних стадиях рак желудка либо не имеет симптомов вообще, либо маскируется под другие заболевания. Ухудшение аппетита и боли под ложечкой редко заставляют сразу же подозревать онкозаболевание. Обычно человек ограничивается диетой и препаратами для улучшения пищеварения. Если у пациента уже имеется хроническое заболевание желудка, то он может воспринять симптомы рака как признаки обострения.

В дальнейшем нарастают более яркие, «кричащие» признаки. Они зависят от того, в какой части органа находится опухоль:
- Дисфагия. Возникает, если новообразование сдавливает место перехода желудка в пищевод. Сначала становится сложно глотать твердую пищу, затем и жидкую.
- Рвота недавно съеденной пищей. Характерна для опухолей в нижней части желудка, в месте перехода в двенадцатиперстную кишку.
- Стойкая изжога.
- Постоянные боли в области желудка, которые отдают в спину. Они не проходят ни днем, ни ночью.
- Потеря веса.
- Увеличение живота. Возникает из-за асцита — скопления жидкости в брюшной полости.
- Под ложечкой можно почувствовать и нащупать жесткое выпирающее образование. Это — опухоль, которая срослась с передней брюшной стенкой.
Со временем в опухоли начинаются процессы изъязвления и распада, развивается желудочное кровотечение. Проявляется оно в виде черного дегтеобразного стула, рвоты, которая выглядит как «кофейная гуща» или содержит примеси алой крови. Если человек теряет много крови, он становится бледным, возникает слабость, головокружение. У некоторых людей рак диагностируется, когда их приводят в клинику в таком состоянии на машине «Скорой помощи».
Как вовремя диагностировать заболевание? Что такое скрининг, и почему он важен?
Статистика говорит о том, что в 75% случаев рак желудка диагностируют уже на распространенной стадии, когда опухоль успевает прорасти в соседние ткани, дать метастазы. Лечить таких больных сложно, прогноз, как правило, неблагоприятный. Обычно выраженные симптомы говорят о том, что рак уже успел распространиться по организму.
Как проверить желудок на рак: на ранних стадиях помогает скрининг — регулярные обследования людей, которые не испытывают никаких симптомов. В качестве скринингового исследования применяют гастроскопию — эндоскопическое исследование, во время которого в желудок вводят гибкую трубку с миниатюрной видеокамерой и лампочкой на конце. Насколько эффективна гастроскопия? Лучше всего это демонстрирует японский опыт. Распространенность рака желудка в Японии очень высока, а смертность от него одна из самых низких в мире. Достичь этого удалось благодаря внедрению массового скрининга.
В клиниках «Евроонко» существуют специальные скрининговые программы, которые помогают вовремя диагностировать разные онкологические заболевания. Посетите врача, узнайте о своих рисках и получите индивидуальные рекомендации по поводу скрининга.

Какие методы диагностики может назначить врач?
Помимо гастроскопии, программа диагностики рака желудка может включать:
- Рентгенографию, перед которой пациенту дают выпить контрастный раствор. При этом контуры желудка хорошо видны на снимках.
- Компьютерную томографию, позитронно-эмиссионную томографию.
- Диагностическую лапароскопию. Это операция, во время которой в живот пациента через отверстия вводят лапароскоп с миниатюрной видеокамерой и специальные инструменты. Процедура помогает оценить, как далеко за пределы желудка успел распространиться процесс.
- Биопсию. Врач получает образец подозрительной ткани и отправляет в лабораторию для изучения под микроскопом. Этот метод диагностики помогает максимально точно диагностировать онкологическое заболевание и установить тип рака. Биопсию можно провести во время гастроскопии, хирургического вмешательства.

Современные принципы лечения рака желудка
Основной метод лечения рака желудка — хирургический. Объем операции зависит от того, на какой стадии обнаружена опухоль. Если она не успела распространиться вглубь стенки органа, проводят эндоскопическую резекцию — удаление пораженного участка при помощи инструмента, введенного через рот, как во время гастроскопии.
При субтотальной гастрэктомии удаляют часть органа, пораженную опухолевым процессом. На более поздних стадиях орган приходится удалять целиком вместе с окружающими тканями. При этом пищевод соединяют с тонкой кишкой. Если лимфатические узлы в брюшной полости поражены метастазами, их также нужно удалить.
В запущенных случаях, когда излечение невозможно, проводят паллиативную операцию. Хирург удаляет пораженную часть желудка, чтобы облегчить состояние пациента.
Лучевая терапия при раке желудка бывает:
- неоадъювантной — проводится перед операцией, чтобы уменьшить размеры опухоли и облегчить её удаление;
- адъювантной — чтобы уничтожить раковые клетки, которые остались в организме после операции.
Наиболее распространенные побочные эффекты лучевой терапии при облучении области живота: тошнота, нарушение пищеварения, диарея.
Химиотерапия также бывает адъювантной и неоадъювантной. Часто её сочетают с лучевой терапией. Химиолучевая терапия может стать основным методом лечения при метастатическом раке на поздних стадиях, когда прогноз неблагоприятный, но есть возможность облегчить симптомы и продлить жизнь больного.
В некоторых случаях эффективны таргетные препараты: трастузумаб, рамуцирумаб, иматиниб, сунитиниб, регорафениб. Но они подходят лишь в тех случаях, когда опухолевые клетки обладают определенными молекулярно-генетическими свойствами.
Какой прогноз при раке желудка?
Прогноз при раке желудка зависит от стадии опухоли, на которой был установлен диагноз и начато лечение. Шансы на стойкую ремиссию наиболее высоки, если опухоль не проросла за пределы слизистой оболочки и подслизистой основы. При метастазах прогноз, как правило, неблагоприятен.
В онкологии существует такой показатель, как пятилетняя выживаемость. Он показывает, какой процент больных остаются живы в течение 5-ти лет. Срок достаточно большой, в определенном смысле его можно приравнять к выздоровлению. Пятилетняя выживаемость при разных стадиях рака желудка составляет:
- I стадия — 57-71%;
- II стадия — 33-46%;
- III стадия — 9-20%;
- IV стадия — 4%.
Некоторые цифры и факты:
- Эксперты Всемирной организации здравоохранения (ВОЗ) утверждают, что ежегодно от рака желудка во всем мире погибают 754 000 людей.
- В XXI веке распространенность заболевания снижается, но в разных странах неодинаково. Так, на одного больного из Великобритании приходится двое из России и трое из Японии.
- По распространенности среди прочих онкозаболеваний рак желудка занимает пятое место, но среди причин смерти — третье.
- Одна из лидирующих стран по распространенности рака – Япония, во многом за счет характера питания.
В клиниках «Евроонко» применяются наиболее современные методы лечения рака желудка и других онкологических заболеваний. Даже если прогноз неблагоприятен, это не означает, что больному ничем нельзя помочь. Наши врачи знают, как облегчить симптомы, обеспечить приемлемое качество жизни, продлить жизнь
Диагностика и лечение рака кишечника
Рак кишечника имеет второе название – колоректальный рак. Злокачественные новообразования чаще развиваются в прямой, сигмовидной, нисходящей и восходящей кишке. Реже патологию выявляют в поперечной, слепой кишке, аппендиксе и тонком кишечнике. В Юсуповской больнице раннюю диагностику рака кишечника проводят с помощью новейших диагностических процедур и точных методов лабораторной диагностики.

array(6) < ["ID"]=>string(5) "29118" ["WIDTH"]=> int(620) ["HEIGHT"]=> int(570) ["SRC"]=> string(94) "/upload/sprint.editor/936/img-1653219736-7032-684-ccb3e9820299a49b6f51a70114251f81-%281%29.jpg" ["ORIGIN_SRC"]=> string(94) "/upload/sprint.editor/936/img-1653219736-7032-684-ccb3e9820299a49b6f51a70114251f81-%281%29.jpg" ["DESCRIPTION"]=> string(0) "" >
При выявлении злокачественной опухоли кишечника в виде рака в начальной стадии онкологического процесса врачи клиники онкологии проводят комплексную терапию. Она включает следующие компоненты:
- Инновационные оперативные вмешательства;
- Химиотерапию эффективнейшими лекарственными средствами, обладающими минимальным спектром побочных эффектов;
- Лучевую терапию с помощью новейшей аппаратуры, позволяющей целенаправленно воздействовать на опухоль, не повреждая окружающие ткани.
При отсутствии технической возможности провести радикальную операцию проводят паллиативные хирургические вмешательства.
Причины возникновения рака кишечника
Причины рака кишечника еще находятся на стадии изучения. Существуют определенные факторы, которые могут увеличивать вероятность развития раковых новообразований. Эти же факторы влияют на то, как долго развивается рак кишечника. К данным факторам относятся:
Причины
Описание
Генетическая предрасположенность к развитию рака автоматически включает человека в группу риска. При наличии рака в семейном анамнезе человеку необходимо особенно бережно относиться к своему здоровью, вовремя лечить заболевания.
Различные болезни кишечника
Развитию рака часто предшествуют воспалительные и опухолевые заболевания слизистой оболочки кишечника: полипы, аденомы, болезни Крона, язвенный колит. Данные заболевания не являются злокачественными, но могут создавать условия для появления раковых клеток.
Употребление в пищу слишком жирной пищи, большого количества простых углеводов, отсутствие продуктов с клетчаткой приводит к появлению запоров. Плотные каловые массы способны нарушать целостность стенок кишечника, вызывая микротрещины и нарушая его работу. Это может приводить к перерождению здоровых клеток в злокачественные.
Сигареты, алкоголь, наркотики являются канцерогенами и провоцируют перерождение клеток.
Влияние окружающей среды
Загрязненная атмосфера, постоянный контакт с вредными веществами (асбест, ртуть и др.), способны вызывать рак различных органов и систем.
Сколько развивается рак кишечника – вопрос индивидуальный. Это будет зависеть от общего состояния здоровья человека и интенсивности влияния провоцирующего фактора.
Какой бывает рак в кишечнике
В соответствии с Международной классификацией болезней (МКБ 10), рак кишечника разделяют на следующие основные виды:
В злокачественную опухоль может переродиться доброкачественное новообразование – аденома кишечника. Она образуется у пациентов, которые страдают хроническим колитом, язвой или гастритом. В кишечнике образуются и другие доброкачественные новообразования: полипы, фибромы, липомы, ангиомы.
Стадии рака кишечника
Выделяют 4 стадии рака кишечника. Они отличаются в зависимости от степени прогрессирования заболевания и клинических проявлений. На 1-2 стадиях симптомы бывают незаметны для больного, хотя в это время онкологический процесс поражает все больше здоровой ткани. В этом и заключается сложность рака кишечника. Больной обращается к врачу на 3-4 стадиях, когда заболевание уже очень сложно вылечить.
Клиницисты выделяют 4 стадии рака кишечника:
На первой стадии рака заболевание не проявляется клиническими симптомами. Незначительные признаки интоксикации пациент относит к обычному недомоганию. На слизистой кишечника или под слизистой оболочкой образуется небольшое плотное образование. Метастазы в лимфатические узлы отсутствуют.
На второй стадии рака опухоль перекрывает просвет кишечника на треть или половину. Могут поражаться ближайшие к новообразованию лимфатические узлы, но отдалённых метастазов нет.
Третья стадия рака кишечника проявляется нарушением работы кишечника, которое вынуждает человека обратиться к врачу. Злокачественное новообразование перекрывает просвет кишечника полностью или на одну треть. Атипичные клетки выявляют в удалённых от опухоли лимфатических узлах. Метастазы отсутствуют.

array(6) < ["ID"]=>string(5) "29120" ["WIDTH"]=> int(1024) ["HEIGHT"]=> int(684) ["SRC"]=> string(65) "/upload/sprint.editor/423/img-1653219902-4931-474-bezymyannyy.jpg" ["ORIGIN_SRC"]=> string(65) "/upload/sprint.editor/423/img-1653219902-4931-474-bezymyannyy.jpg" ["DESCRIPTION"]=> string(0) "" >
Симптомы рака кишечника
Колоректальный рак имеет множество клинических проявлений, что иногда становится причиной диагностических ошибок. Большую роль в выявлении рака кишечника на ранней стадии играет профессионализм врачей, которые впервые сталкиваются с пациентом. Симптоматика заболевания включает появление крови в кале, боли или неприятные ощущения в области живота, диарею, потерю веса. Симптоматика развития опухоли кишечника имеет схожесть с симптомами хронического расстройства пищеварения, симптомами других заболеваний – это часто становится причиной несвоевременной постановки диагноза.

array(6) < ["ID"]=>string(5) "29121" ["WIDTH"]=> int(1024) ["HEIGHT"]=> int(931) ["SRC"]=> string(62) "/upload/sprint.editor/68d/img-1653219935-6727-575-rakkish3.jpg" ["ORIGIN_SRC"]=> string(62) "/upload/sprint.editor/68d/img-1653219935-6727-575-rakkish3.jpg" ["DESCRIPTION"]=> string(0) "" >
На ранней стадии заболевания пациенты предъявляют жалобы на хроническую усталость, редкие или частые позывы к дефекации. В анализе крови уменьшается количество эритроцитов и гемоглобина. Вначале терапевты не могут установить причины прогрессирующей анемии. В связи с тем, что симптоматика рака кишечника схожа с признаками других заболеваний, вызывающих хроническое расстройство пищеварения, врачи часто несвоевременно устанавливают точный диагноз. Если опухоль перекрывает просеет кишки, развивается кишечная непроходимость. Она проявляется прекращением отхождения кала и газов, вздутием кишечника. Развиваются признаки «острого живота». В этом случае хирурги выполняют ургентную операцию.
Первые признаки и симптомы рака кишечника на ранней стадии
Степень выраженности симптомов рака кишечника возрастает по мере роста и распространения опухоли. Первые признаки рака кишечника на ранней стадии почти не привлекают внимания больного, слабо выражены. Патологические признаки, которые указывают на развитие злокачественного заболевания – это появление слизи и крови в кале.
В начале проявления опухоли кровь выделяется в виде прожилок, затем количество крови в кале возрастает, появляются сгустки, иногда со зловонным запахом. Цвет кровянистых выделений – от темного окраса до почти черного цвета. Очень часто у больных раком кишечника в начальных стадиях роста опухоли развивается тахикардия.
Проявления рака кишечника в зависимости от его вида
Морфологи различают следующие гистологические виды рака кишечника:
Аденокарцинома чаще локализуется в толстой кишке. Она проявляется быстрой утомляемостью, повышением температуры тела, постоянными запорами, интенсивными болями в животе.
При наличии карциномы кишечника у пациентов возникает боль и ощущение распирания в животе, запоры или поносы. У них ухудшается аппетит, появляются слизистые и кровянистые выделения из заднего прохода.

array(6) < ["ID"]=>string(5) "29122" ["WIDTH"]=> int(1024) ["HEIGHT"]=> int(655) ["SRC"]=> string(62) "/upload/sprint.editor/485/img-1653220000-5732-790-rakkish4.jpg" ["ORIGIN_SRC"]=> string(62) "/upload/sprint.editor/485/img-1653220000-5732-790-rakkish4.jpg" ["DESCRIPTION"]=> string(0) "" >
Лимфома кишечника проявляется отсутствием аппетита, тошнотой, вздутием живота, хронической усталостью. У пациентов увеличивается образование в кишечнике газов, повышается температура тела, развивается анемия.
Для саркомы характерны расстройства стула, появление изжоги, крови в кале. Пациентов беспокоит боль при прохождении каловых масс через кишечник, интенсивные боли внизу живота, периодические боли, которые возникают после принятия неудобной позы или еды.
Рак кишечника у женщин и мужчин
Признаки онкологии кишечника у мужчин и женщин встречаются одинаково часто, они совсем немного уступают раку груди у женщин и раку желудка и легких у мужчин.
Первые признаки рака кишечника у женщин
У женщин онкологи чаще выявляют рак ободочной кишки. Симптомы рака кишечника у женщин могут появиться в любом возрасте, но риск его развития возрастает после 40 лет. Самый высокий процент заболевших отмечается в возрасте от 60 лет и старше.
Наиболее частая причина рака ободочной кишки у женщин – перерождение кишечных полипов. Опухоль чаще возникает у женщин с отягощённой наследственностью, ведущих малоподвижный образ жизни, употребляющих в пищу много мяса (особенно говядины).
Симптомы заболевания появляются спустя два года от начала развития патологического процесса. Пациенток беспокоит боль в животе, вздутие, нарушение стула. При прогрессировании болезни опухоль даёт метастазы в лимфатические узлы, влагалище и другие органы.

array(6) < ["ID"]=>string(5) "29123" ["WIDTH"]=> int(732) ["HEIGHT"]=> int(549) ["SRC"]=> string(63) "/upload/sprint.editor/e56/img-1653220083-3356-581-rakkish10.jpg" ["ORIGIN_SRC"]=> string(63) "/upload/sprint.editor/e56/img-1653220083-3356-581-rakkish10.jpg" ["DESCRIPTION"]=> string(0) "" >
На ранних стадиях развития рака кишечника симптомы и проявления у женщин не отличаются от симптомов заболевания раком у мужчин. Появляются запоры, боль может отдавать в область прямой кишки. Более поздние проявления рака кишечника характеризуются недержанием стула, сильными болями в области кишечника, боли могут беспокоить в области влагалища, заднепроходного отверстия.
Развивается рвота, появляются урогенитальные свищи. Метастазирование опухоли в область мочевого пузыря проявляется новыми симптомами – изменением мочи. Моча становится мутной, приобретает запах кала. Из-за постоянных кровотечений развивается анемия, может развиться тяжелая форма заболеваний мочевого пузыря и почек.
У женщин дополнительно могут возникать нарушения менструального цикла, изменение вкусовых предпочтений.
Причины и симптомы рака кишечника у мужчин
У мужчин чаще встречается рак прямой кишки. Заболевание просто диагностировать, но в связи с тем, что его симптомы напоминают признаки другой патологии кишечника, пациенты поздно обращаются за медицинской помощью. Причины визита к врачу, следующие:
Кровь на поверхности кала;
Изменение формы и консистенции каловых масс;
Боль в заднем проходе;
Поносы или запоры.
Симптомы рака кишечника у мужчин являются классическими и сочетают в себе нарушение работы ЖКТ, но при метастазировании часто поражается простата.
При пальцевом исследовании проктологи определяют опухолевидное образование. Наиболее частая причина рака кишечника у мужчин – курение, злоупотребление спиртными напитками, кулинарные предпочтения (употребление в пищу жирной, острой, жареной пищи). Рак кишечника у мужчин может развиться на фоне полипов кишечника, неспецифического язвенного колита, ожирения, нелеченного геморроя.
Метастазы
При раке кишечника чаще всего первой метастазируется печень. Это происходит на 4-ой стадии заболевания. Прогноз рака кишечника 4 стадии с метастазами будет зависеть от степени поражения тканей и органов. При прохождении лечения и соблюдении рекомендаций врача больной может прожить еще около 2-х лет.
Метастазы рака кишечника 4 стадии могут поражать забрюшинное пространство и брюшину, органы малого таза, поджелудочную железу, мочевой пузырь, легкие. Неблагоприятные симптомы метастазов в кишечнике будут следующими:
Прорастание опухоли в жировую клетчатку;
Перфорирование толстой кишки;
Распространение раковых клеток на соседние органы;
Наличие раковых клеток с низкой степенью дифференцировки.
Диагностика рака кишечника
Очень важна точная диагностика рака кишечника для составления адекватной результативной терапии. В Юсуповской больнице онкологи проводят диагностику рака кишечника с помощью современного оборудования, обладающего высокой разрешающей способностью. Обследование пациента начинают с пальцевого исследования прямой кишки. Этот простой диагностический метод позволяет выявить рак прямой кишки.
Затем гастроэнтерологи применяют рентгенологические и эндоскопические методы исследования: ректороманоскопию, колоноскопию. Во время ректороманоскопии врач проводит осмотр слизистой оболочки прямой кишки. В некоторых случаях исследуются дистальные отделы сигмовидной кишки. С помощью колоноскопии оценивают состояние толстой кишки. Во время эндоскопического исследования хирург проводит биопсию обнаруженных новообразований. Фрагменты патологически изменённых тканей отправляют на гистологическое исследование.

array(6) < ["ID"]=>string(5) "29125" ["WIDTH"]=> int(1024) ["HEIGHT"]=> int(662) ["SRC"]=> string(62) "/upload/sprint.editor/ee6/img-1653220180-2697-672-rakkish9.jpg" ["ORIGIN_SRC"]=> string(62) "/upload/sprint.editor/ee6/img-1653220180-2697-672-rakkish9.jpg" ["DESCRIPTION"]=> string(0) "" >
Для ранней диагностики рака кишечника в Юсуповской больнице определяют уровень онкомаркеров – белковых соединений, которые вырабатываются в организме при развитии опухолевого процесса:
СА19-9, CA 72-4, LASA – P – маркеры рака желудочно-кишечного тракта;
CA 125 – позволяет выявить новообразования сигмовидной кишки;
CYFRA 21-1 – образуется при наличии рака прямой кишки.
SCC – позволяет выявить плоскоклеточный рак анального канала.
CA 242 – определяется в случае образования рака прямой и толстой кишки.
АФП – образуется при опухолях прямой и сигмовидной кишки;
РЭА – является чувствительным маркером рака толстой кишки.
С помощью онкомаркеров можно заподозрить рак кишечника до появления клинических проявлений заболевания.
Как лечится рак в кишечнике
Лечение рака кишечника является комплексным. Оно включает оперативное вмешательство и последующую химио-, радио- или лучевую терапию, а также реабилитацию. Многолетний опыт онкологов Юсуповской больницы помогает достигать оптимального эффекта лечения даже в самых сложных случаях.
Методами лечения рака кишечника являются:
- Хирургическое вмешательство. Операция может выполняться абдоминальным (открытым) способом, а также малоинвазивными методами: эндоскопия, лапароскопия, радиохирургия (гамма-нож и кибер-нож). Выбор метода лечения будет зависеть от стадии заболевания, локализации опухоли, ее размеров. Прогноз после операции опухоли кишечника значительно улучшается, поскольку снижается вероятность метастазирования;
- Лучевая и радиотерапия терапия при раке кишечника. Назначаются для остановки роста злокачественных клеток и прогрессирования заболевания. Могут применяться до и после операции;
- Химиотерапия при раке кишечника. В лечении используется ряд препаратов, вызывающих гибель раковых клеток. Данные препараты негативно влияют и на здоровые клетки, поэтому у химиотерапии есть много неприятных побочных реакций (выпадение волос, постоянная рвота). Для поддержки организма параллельно назначают иммуностимуляторы.
Прогноз
При опухоли (аденокарцинома, карцинома, саркома) кишечника продолжительность жизни будет зависеть от масштабов развития онкологического процесса. Прогноз рака кишечника напрямую зависит от того, на какой стадии было начало лечение. На результаты терапии также могут влиять дополнительные факторы:
- Возраст пациента;
- Состояние его организма;
- Реакция на проводимое лечение;
- Сопутствующие заболевания.
- Первая стадия: 95%;
- Вторая стадия: 75%;
- Третья стадия: 50%;
- Четвертая стадия: 5%.
В настоящее время не существует препаратов, которые могли бы предотвратить рак кишечника. Профилактика злокачественных опухолей состоит из комплекса мероприятий:
Отказа от вредных привычек;
Умеренных физических нагрузок;
Контроля хронических заболеваний;
Рекомендации по лечению рака кишечника
В Москве успешное лечение рака кишечника выполняют в Юсуповской больнице. Это многопрофильный медицинский центр, который специализируется на лечении онкологических заболеваний и выполнении реабилитации пациентов. В больнице создано специальное отделение – клиника онкологии, где работают лучшие специалисты Москвы, занимающиеся лечением рака любой локализации и стадии. Высокая квалификация и большой опыт врачей, современное оснащение позволяют выполнять лечение рака кишечника любой сложности и добиваться максимального результата.
Список литературы
Профильные специалисты
Заведующая терапевтическим отделением. Врач-терапевт, кардиолог, онколог.
Читайте также:
